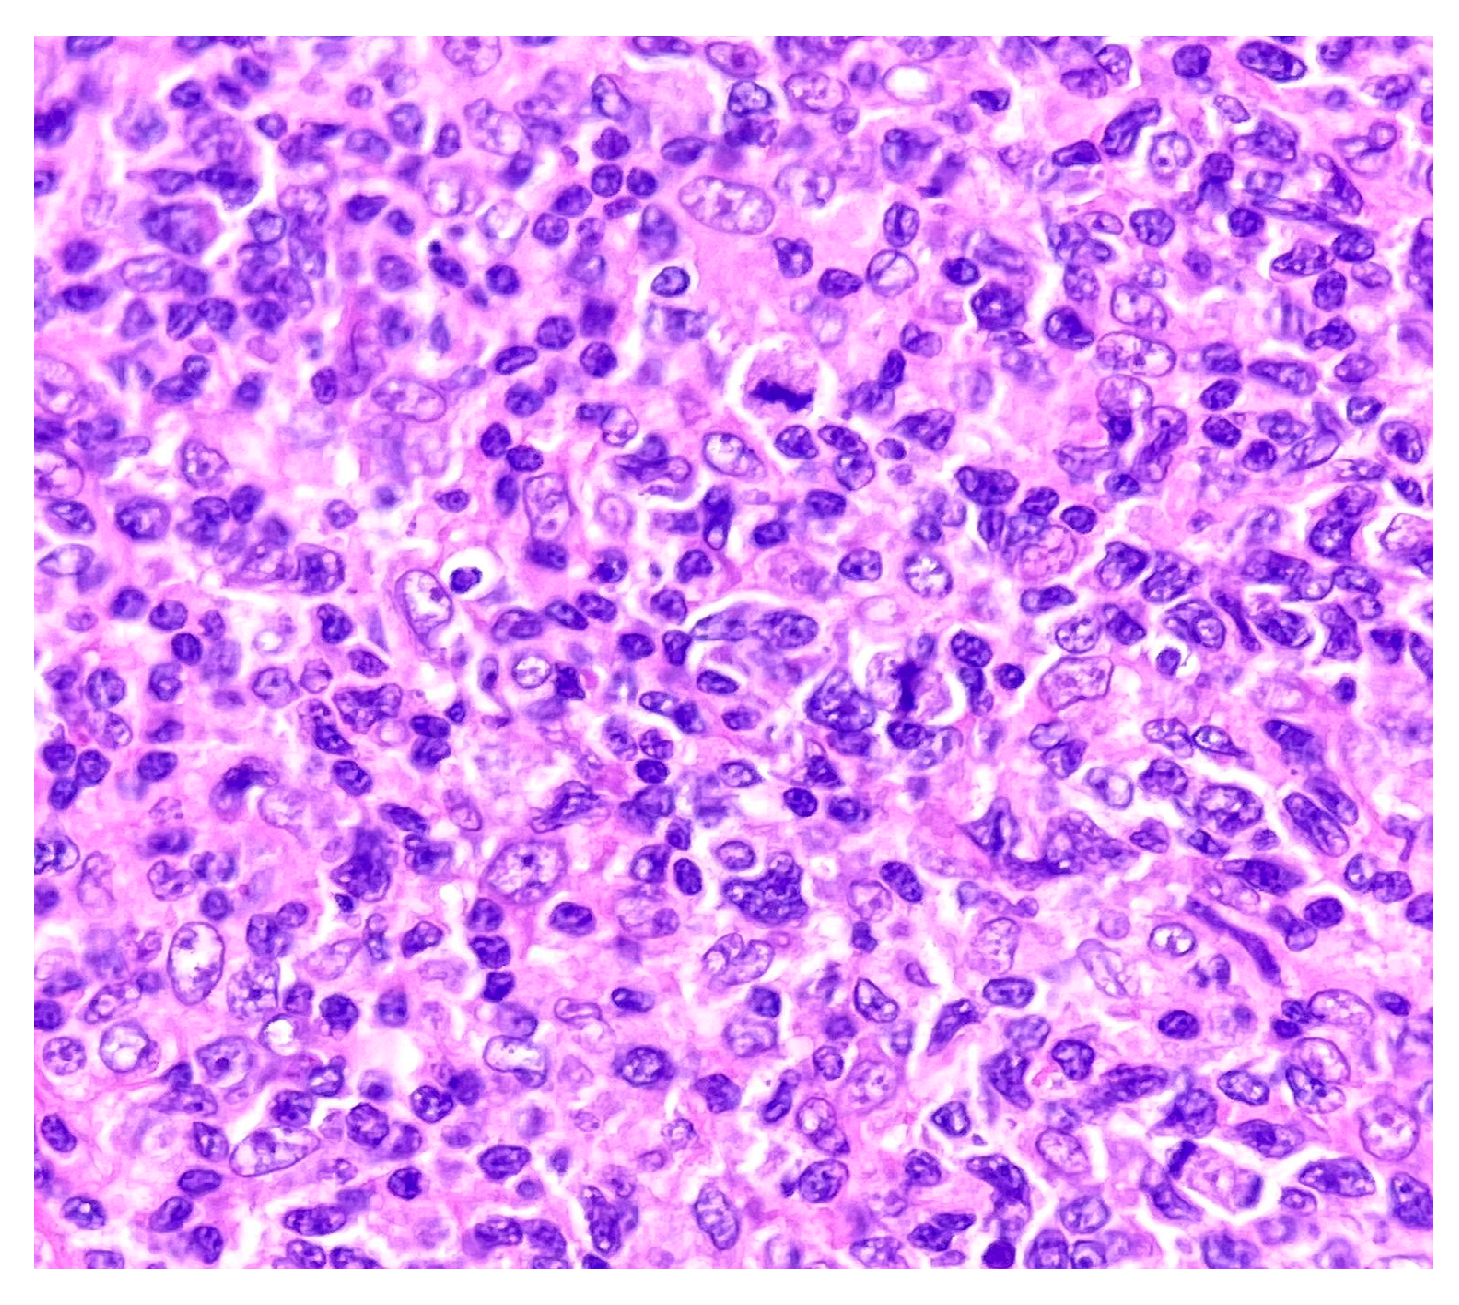
Medicina 58 01618 g003 Medicina 58 01618 g003

Surgical, Dermatological and Morphopathological Considerations in the Diagnosis and Treatment of Cutaneous Lymphoproliferative Tumors, Primary CD4+
Abstract
1. Introduction
2. Case Report
3. Discussion
4. Conclusions
Author Contributions
Funding
Institutional Review Board Statement
Informed Consent Statement
Data Availability Statement
Conflicts of Interest
References
- Willemze, R.; Cerroni, L.; Kempf, W.; Berti, E.; Facchetti, F.; Swerdlow, S.H.; Jaffe, E.S. The 2018 update of the WHO-EORTC classification for primary cutaneous lymphomas. Blood 2019, 133, 1703–1714. [Google Scholar] [CrossRef] [PubMed]
- Ardeleanu, V.; Georgescu, C.; Frîncu, L.D.; Frâncu, L.L.; Vesa, D. Angiogenesis as Prospective Molecular Biology Technique for Cancer Study. Rom. Biotehnol. Lett. 2014, 19, 9367–9648. [Google Scholar]
- Teeling, J.L.; Mackus, W.J.; Wiegman, L.J.; van den Brakel, J.H.; Beers, S.A.; French, R.R.; van Meerten, T.; Ebeling, S.; Vink, T.; Slootstra, J.W.; et al. The biological activity of human CD20 monoclonal antibodies is linked to unique Epitopeson CD20. J. Immunol. 2006, 177, 362–371. [Google Scholar] [CrossRef] [PubMed]
- Jak, M.; van Bochove, G.G.; Reits, E.A.; Kallemeijn, W.W.; Tromp, J.M.; Umana, P.; Klein, C.; van Lier, R.A.; van Oers, M.H.; Eldering, E. CD40 stimulation sensitizes CLL cells to lysosomal cell death induction by type II anti-CD20 mAb GA101. Blood 2011, 118, 5178–5188. [Google Scholar] [CrossRef] [PubMed][Green Version]
- Dong, D.; Zheng, L.; Lin, J.; Zhang, B.; Zhu, Y.; Li, N.; Xie, S.; Wang, Y.; Gao, N.; Huang, Z. Structural basis of assembly of the human T cell receptor–CD3 complex. Nature 2019, 573, 546–552. [Google Scholar] [CrossRef]
- Walker, L.S.; von Herrath, M. CD4 Tcell differentiation in type 1 diabetes. Clin. Exp. Immunol. 2016, 183, 16–29. [Google Scholar] [CrossRef]
- Enache, I.; Ioniţă, E.; Anghelina, F.; Mogoantă, C.A.; Ciolofan, M.S.; Căpitănescu, A.N.; Vîlcea, A.M.; Florescu, A.M.; Simionescu, C.E. Involvement of inflammatory cells in chronic rhinosinusitis with nasal polyps. Rom. J. Morphol. Embryol. 2020, 61, 871–877. [Google Scholar] [CrossRef]
- Ostroumov, D.; Fekete-Drimusz, N.; Saborowski, M.; Kühnel, F.; Woller, N. CD4 and CD8 T lymphocyte interplay in controlling tumor growth. Cell. Mol. Life Sci. 2018, 75, 689–713. [Google Scholar] [CrossRef]
- Pierce, J.M.; Mehta, A. Diagnostic, prognostic and therapeutic role of CD30 in lymphoma. Expert Rev. Hematol. 2017, 10, 29–37. [Google Scholar] [CrossRef]
- Heeren, A.M.; Koster, B.D.; Samuels, S.; Ferns, D.M.; Chondronasiou, D.; Kenter, G.G.; Jordanova, E.S.; de Gruijl, T.D. High and interrelated rates of PD-L1+CD14+ antigen-presenting cells and regulatory T cells mark the microenvironment of metastatic lymph nodes from patients with cervical cancer. Cancer Immunol Res. 2015, 3, 48–58. [Google Scholar] [CrossRef]
- Marinescu, S.A.; Tatu, A.L.; Mihai, I.R.; Giuglea, C. Correlations between clinics, dermoscopy and histopathology in a female with two dermatofibromas-a case report. Rom. J. Morphol. Embryol. 2016, 57, 323–326. [Google Scholar] [PubMed]
- Vitiello, P.; Sica, A.; Ronchi, A.; Caccavale, S.; Franco, R.; Argenziano, G. Primary cutaneous B-cell lymphomas: An update. Front. Oncol. 2020, 10, 651. [Google Scholar] [CrossRef] [PubMed]
- Chandler, J.B.; Waldman, R.; Sloan, S.B.; Rose, M.G.; Wong, E.Y. Cutaneous marginal zone lymphoma following anthrax vaccination. Ann. Hematol. 2021, 100, 3079–3080. [Google Scholar] [CrossRef] [PubMed]
- Gru, A.A.; Wick, M.R.; Eid, M. Primary cutaneous CD4+ small/medium T-cell lymphoproliferative disorder-clinical and histopathologic features, differential diagnosis, and treatment. Semin. Cutan. Med. Surg. 2018, 37, 39–48. [Google Scholar] [CrossRef] [PubMed]
- Tatu, A.L.; Nwabudike, L.C. Rosacea-like demodicosis (but not primary demodicosis) and papulo pustular rosacea may be two phenotypes of the same disease-a microbioma, therapeutic and diagnostic tools perspective. J. Eur. Acad. Dermatol. Venereol. 2019, 33, e46–e47. [Google Scholar] [CrossRef] [PubMed]
- Geller, S.; Marghoob, A.A.; Scope, A.; Braun, R.P.; Myskowski, P.L. Dermoscopy and the diagnosis of primary cutaneous B-cell lymphoma. J. Eur. Acad. Dermatol. Venereol. 2018, 32, 53–56. [Google Scholar] [CrossRef]
- Piccolo, V.; Russo, T.; Agozzino, M.; Vitiello, P.; Caccavale, S.; Alfano, R.; Argenziano, G. Dermoscopy of cutaneous lymphoproliferative disorders: Where are we now? Dermatology 2018, 234, 131–136. [Google Scholar] [CrossRef]
- Rémy-Leroux, V.; Léonard, F.; Lambert, D.; Wechsler, J.; Cribier, B.; Thomas, P.; Adamski, H.; Marguery, M.C.; Aubin, F.; Leroy, D.; et al. Comparison of histopathologic-clinical characteristics of Jessner’s lymphocytic infiltration of the skin and lupus erythematosus tumidus: Multicenter study of 46 cases. J Am Acad Dermatol. 2008, 58, 217–223. [Google Scholar] [CrossRef]
- Wilcox, R.A. Cutaneous B-cell lymphomas: 2019 update on diagnosis, risk stratification, and management. Am. J. Hematol. 2018, 93, 1427–1430. [Google Scholar] [CrossRef]
- Ronchi, A.; Sica, A.; Vitiello, P.; Franco, R. Dermatological Considerations in the Diagnosis and Treatment of Marginal Zone Lymphomas. Clin. Cosmet. Investig. Dermatol. 2021, 14, 231–239. [Google Scholar] [CrossRef]
- Luca, D. Primary Cutaneous CD4+ Small/Medium. Available online: https://www.pathologyoutlines.com/topic/lymphomanonBcutaneouscd4.html (accessed on 8 April 2021).
- Kubiak, K.; Sielawa, H.; Chen, W.; Dzika, E. Endosymbiosis and its significance in dermatology. J. Eur. Acad. Dermatol. Venereol. 2018, 32, e346–e347. [Google Scholar] [CrossRef] [PubMed]
- Tatu, A.L.; Nadasdy, T.; Nwabudike, L.C. Chitin-lipid interactions and the potential relationship between Demodex and SARS-CoV-2. Dermatol. Ther. 2021, 34, e14935. [Google Scholar] [CrossRef] [PubMed]
- Curis, C.; Ciubară, A.B.; Nechita, A.; Nechita, L.; Kantor, C.; Moroianu, L.A. The role of motivational interview in treatment acceptance–case report. Med.-Surg. J. 2018, 122, 375–380. [Google Scholar]

| Antibody | Clone | Producer | Pretreatment | Dilution |
|---|---|---|---|---|
| CD3 | MRQ-39 | Cell Marque | HIER EDTA 19 min | 1:100 |
| CD4 | EP204 | Cell Marque | HIER EDTA 19 min | 1:200 |
| CD8 | C8/144B | Cell Marque | HIER EDTA 19 min | 1:200 |
| CD20 | L26 | Cell Marque | HIER EDTA 19 min | 1:100 |
| CD30 | Ber-H2 | Bio SB | HIER EDTA 19 min | 1:100 |
| Ki67 | MIB-1 | DAKO | HIER EDTA 19 min | 1:200 |
| PD1 | NAT105 | Cell Marque | HIER EDTA 19 min | 1:100 |
Publisher’s Note: MDPI stays neutral with regard to jurisdictional claims in published maps and institutional affiliations. |
© 2022 by the authors. Licensee MDPI, Basel, Switzerland. This article is an open access article distributed under the terms and conditions of the Creative Commons Attribution (CC BY) license (https://creativecommons.org/licenses/by/4.0/).
Share and Cite
Ardeleanu, V.; Moroianu, L.-A.; Sava, A.; Tebeica, T.; Jecan, R.C.; Moroianu, M.; Tatu, A.L. Surgical, Dermatological and Morphopathological Considerations in the Diagnosis and Treatment of Cutaneous Lymphoproliferative Tumors, Primary CD4+. Medicina 2022, 58, 1618. https://doi.org/10.3390/medicina58111618
Ardeleanu V, Moroianu L-A, Sava A, Tebeica T, Jecan RC, Moroianu M, Tatu AL. Surgical, Dermatological and Morphopathological Considerations in the Diagnosis and Treatment of Cutaneous Lymphoproliferative Tumors, Primary CD4+. Medicina. 2022; 58(11):1618. https://doi.org/10.3390/medicina58111618
Chicago/Turabian StyleArdeleanu, Valeriu, Lavinia-Alexandra Moroianu, Anca Sava, Tiberiu Tebeica, Radu Cristian Jecan, Marius Moroianu, and Alin Laurentiu Tatu. 2022. "Surgical, Dermatological and Morphopathological Considerations in the Diagnosis and Treatment of Cutaneous Lymphoproliferative Tumors, Primary CD4+" Medicina 58, no. 11: 1618. https://doi.org/10.3390/medicina58111618
APA StyleArdeleanu, V., Moroianu, L.-A., Sava, A., Tebeica, T., Jecan, R. C., Moroianu, M., & Tatu, A. L. (2022). Surgical, Dermatological and Morphopathological Considerations in the Diagnosis and Treatment of Cutaneous Lymphoproliferative Tumors, Primary CD4+. Medicina, 58(11), 1618. https://doi.org/10.3390/medicina58111618

